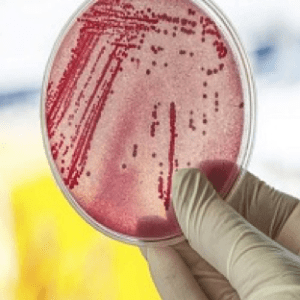

________________________________________________________
-
Greta Thunberg alla conferenza delle Nazioni Unite sul cambiamento climatico in Polonia.

La monografia “AMBIENTE E SALUTE. Inquinamento, interferenze sul genoma umano e rischi per la salute”, a cura di Ernesto Burgio, pubblicata dall’Ordine dei Medici di Arezzo, tratta una tematica rivoluzionaria in ambito biomedico che si ispira ad un’idea originaria di Lorenzo Tomatis e che ISDE Italia ha fatto propria.


The main aim of the workshop held in Modena on 14th and 15th May was the development of an International Network on Public Health Environmental Tracking – INPHET – to strengthen existing networks in environmental health surveillance among national and regional public health institutes, as well as developing new initiatives across both Europe and other continents.
The first step towards the implementation of INPHET was the exchange of knowledge and experience among the participating countries. This exchange took place in interactive working groups, chaired by key international experts in environmental public health, which focused on three main themes:
- Partnerships: strategies and opportunities in developing an international network;
- Science and Data: data availability, indicators, methods and training;
- Ethics and Confidentiality: legal frameworks, relationships with industry, data exchange and confidentiality.

